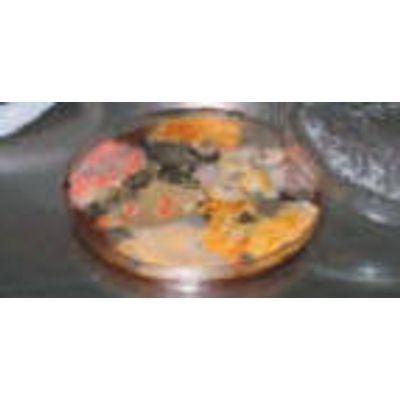

Toledo Testing Laboratory Associates, Inc. (TTL) services
Health & Safety Services
TTL has expanded its services to provide onsite Environmental Health & Safety training and safety services. Our goal is to help you develop the strategy, motivation, and accountability required to succeed in your business.
Environmental Services
Hazardous Materials
Hazardous Material Analysis & RemovalAn experienced team of trained and certified professionals identify and resolve hazardous material problems through professional evaluations, sampling and analysis, management plans, design and management of abatement, indoor air quality sampling, clearance sampling and remediation.
Asbestos Laboratory
TTL provides responsive analysis of suspect and bulk materials for asbestos content via polarized light microscopy (PLM). TTL’s in-house analytical laboratory is accredited by the National Voluntary Laboratory Accreditation Program (NVLAP), NVLAP Lab Code 101594-0.
Indoor Air Quality
Indoor Air Quality AnalysisFrom a simple mold investigation, to an ongoing annual service contract for indoor air quality problems, TTL successfully implements a customized approach for remediation through sampling, analysis, identification, monitoring and abatement.
Industrial Hygiene Programs
Industrial HygieneRecent laws and regulations have fostered an awareness of workplace hazards among employees and the community.